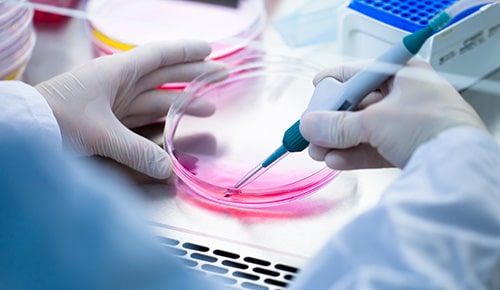
Formation BTS Bioanalyses en laboratoire de contrôle en apprentissage à l'ETSL

Isabelle LOISEAU
Chargée de missions apprentissage
06 83 88 99 85
i.loiseau@afi24.org
Date d'enregistrement certification RNCP : 22/04/2024 | RNCP38884 | Code diplôme : 32022207
Inscription : 15/01/2025 - fin des inscriptions : 01/09/2025 Rentrée : 01/09/2025 Durée de la formation : 1400 heures / 2 ans
Rythme d'alternance
3 semaines à l'école / 3 semaines en entreprise
Contact établissement
Sandra HEUCLIN
Responsable de la formation
s.heuclin@etsl.fr
Conditions d'inscription
Jeune ayant moins de 30 ans à la signature du contrat d'apprentissage.
Bac S, Bac STL, 1ère année d'études supérieures, Bac Général selon options
Modalités
Modalité(s) d'évaluation :
Examen et/ou CCF
Modalités pédagogiques :
Cours théoriques / Travaux pratiques / Travaux dirigés
Procédure de recrutement :
Inscription sur Parcoursup : https://www.parcoursup.fr/
et sur notre site : www.afi24.org,
étude du dossier (CV, lettre de motivation, relevés de notes en votre possession) puis entretien de motivation
| Résultat examen : | 93% | |
| Poursuite d'études : | 64% | |
| Insertion professionnelle : | 75% | |
| Rupture de contrat : | 22% | |
| Rupture de parcours : | 22% |
Les métiers visés : BTS Bio Analyses en Laboratoire de Contrôle
Objectifs de formation : BTS Bio Analyses en Laboratoire de Contrôle
Programme : BTS Bio Analyses en Laboratoire de Contrôle
- ANNÉE 1

Notes :
a : cours en division entière ; b : projets, travaux dirigés et travaux pratiques ;
c : activités technologiques au laboratoire de biotechnologie comportant 15 étudiants au maximum
(1) Horaire de formation à la démarche de projet puis de conception collaborative d’un projet en groupes de 3 à 5 étudiants.
(2) Développement des partenariats par des interventions de professionnels dans la formation et par des visites de laboratoires externes. La dynamique d’échanges avec des professionnels est animée par l’enseignant de biochimie-génie biologique et contribue à développer les compétences du BC4, mais également à consolider les compétences des autres blocs professionnels.
(3) Le coenseignement est pris en charge conjointement par un enseignant de biochimie-génie biologique et par un enseignant de philosophie.
(4) L’accompagnement du tutorat par les pairs suppose un horaire commun entre les étudiants de 1re et de 2e année pour ce temps de formation. Il contribue à la formation sur les 4 blocs professionnels pour les étudiants tutorés, et particulièrement sur le bloc 4 pour les étudiants tuteurs.
(5) L’accompagnement personnalisé s’adresse aux étudiants bacheliers professionnels et à tous les étudiants à besoins identifiés. Les étudiants bénéficiant de l’accompagnement sont identifiés selon les thématiques choisies, suite à des phases de diagnostic organisées par l’équipe éducative. L’accompagnement est effectué à hauteur d’une heure au moins par un enseignant de biochimie-génie biologique. L’horaire est annualisé et effectué majoritairement au premier semestre.
(6) L’horaire de travail en autonomie en démarche de projet figure dans l’emploi du temps des étudiants, et contribue aux mêmes objectifs que l’enseignement de démarche et conception de projet précisé en annexe V-3. Un espace est mis à disposition et l’accès aux ressources numériques et professionnelles est facilité. Le technicien de laboratoire peut superviser l’accès au laboratoire.
Vous souhaitez évoluer dans une équipe dynamique ? avec des valeurs de tolérance, courage, honnêteté et loyauté. C’est ici que ça se passe !
Nous recherchons notre futur(e) apprenti(e) à notre image : dynamique, professionnel, curieux...
Notre groupe biopharmaceutique développe, fabrique et commercialise des médicaments dérivés du sang et des protéines recombinantes pour la prise en charge des patients atteints de pathologies graves et souvent rares.
Nous recherchons pour notre site...
Leader mondial présent dans 27 pays et à travers plus de 100 laboratoires, notre Groupe fait
avancer la science en proposant des solutions pour la qualité et la sécurité alimentaire. Notre vision est
claire : améliorer la...